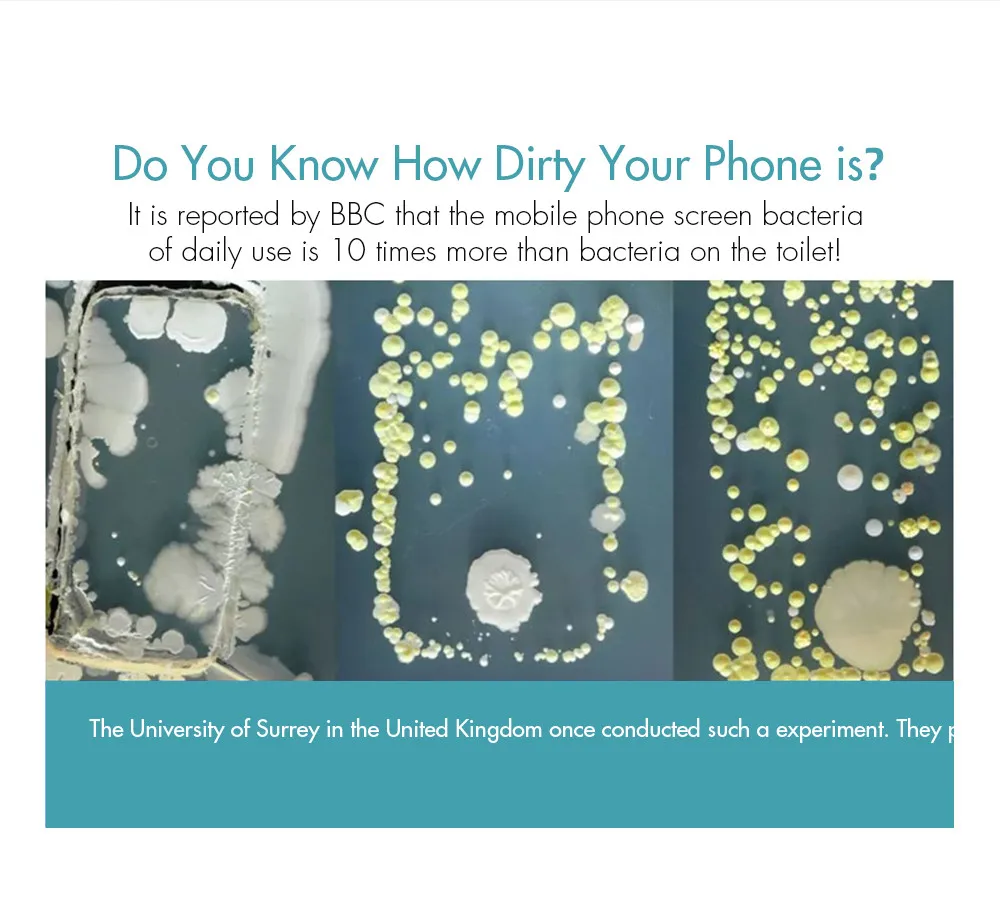

Сохраните в закладки:
*История изменения цены! Указанная стоимость возможно, уже изменилось. Проверить текущую цену - >
| Месяц | Минимальная цена | Макс. стоимость | Цена |
|---|---|---|---|
| Mar-19-2026 | 4244.92 руб. | 4456.29 руб. | 4350 руб. |
| Feb-19-2026 | 4208.11 руб. | 4418.67 руб. | 4313 руб. |
| Jan-19-2026 | 3530.3 руб. | 3707.27 руб. | 3618.5 руб. |
| Dec-19-2025 | 4137.6 руб. | 4344.19 руб. | 4240.5 руб. |
| Nov-19-2025 | 3602.59 руб. | 3782.17 руб. | 3692 руб. |
| Oct-19-2025 | 4065.31 руб. | 4268.86 руб. | 4166.5 руб. |
| Sep-19-2025 | 4030.33 руб. | 4232.36 руб. | 4131 руб. |
| Aug-19-2025 | 3994.19 руб. | 4194.21 руб. | 4094 руб. |
| Jul-19-2025 | 3958.53 руб. | 4156.56 руб. | 4057 руб. |
Новые товары
Характеристики
Описание товара
Магазин дурит покупателей, не советую связываться. ... Читать отзыв полностью...
my height = 183 cm, weight = 93 kg, shoulders = 51 cm, sleeve length = 64 cm. What size... Читать отзыв полностью...
Обожаю всякие вещи в форме деревьев, поэтому данная наклейка в форме ветвей мне сразу приглянулась и я решила ее заказать.... Читать отзыв полностью...
Решила приобрести это замечательное платье себе в подарок на Новый Год. Заказывала черно-розовый цвет. Платье отличное, размер идеально подошел, и... Читать отзыв полностью...
Замечательный набор скатерть и чехлы на стулья заказывала здесь некоторое время назад. И вот хочу сказать что в быту они... Читать отзыв полностью...

Купил у этого магазина пилу.Покупал WOYOFADA,а пришло какое то фуфло.12" шина а пилит только бруски 50*50,и если не применять усилие.Если... Читать отзыв полностью...